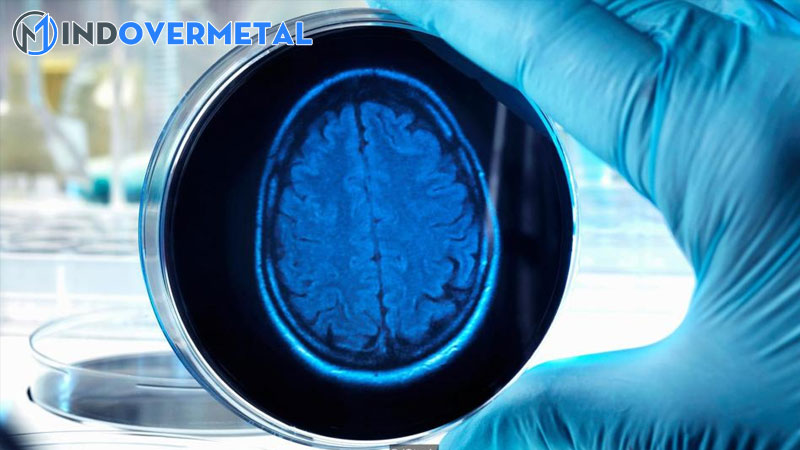
co-the-nuoi-nao-nguoi-ngoai-co-the-1-mindovermetal

Thứ Bảy, ngày 08/10/2016 20 : 19 PM ( GMT + 7 ) Madeleine Lancaster đặt tay lên bụng và nói : ” Cũng được 6-7 tháng rồi đó, nhưng ý cô không phải là em bé, mà hàng trăm tế bào thần kinh đang được nuôi cấy.
Bên trong phòng thí nghiệm tế bào tại Cambridge ( Anh ) trị giá 212 triệu bảng, hiên chạy kính với sắc tố bùng cháy rực rỡ có vẻ như lê dài vô tận như cảnh phim viễn tưởng Hollywood. Ở góc nhỏ của riêng mình tại thiên đường ngoạn mục so với giới khoa học, Madeleine cũng có sáng tạo độc đáo bất khả thi không kém : biến da người thành tế bào não .
” Bộ não tăng trưởng theo chính sách giống như bào thai “, Madeleine nói. Theo đó, não được cung ứng máu và dinh dưỡng liên tục trong thiên nhiên và môi trường vô trùng. Cô mở phòng chứa lồng ấp, để lộ những đốm nhỏ trôi trong vũng chất lỏng màu hồng nhạt, giống như những miếng bỏng ngô. Tuy vậy, chúng có cấu trúc hoàn hảo gồm có chát xám, tức tế bào thần kinh và chất trắng là mô mỡ, với từng vùng khác nhau như đại não, tiểu não … tương tự với mức tăng trưởng của bào thai 9 tuần tuổi .
Hình chụp bộ não mini
Thực ra sản xuất não không quá phức tạp, chỉ mất vài tháng. Nguyên liệu gồm có những tế bào từ bất kỳ bộ phận nào, mũi, gan hay thậm chí còn móng chân. Lancaster lấy nó từ những mẫu da được hiến khuyến mãi ngay. Tuy nhiên chỉ có tế bào gốc mới tăng trưởng thành mọi loại mô của khung hình nên nhóm nghiên cứu và điều tra phải dùng huyết thanh, giống như một loại cocktail protein đảo ngược quy trình tăng trưởng và trẻ hóa mô thành tế bào non .

Sau vài tuần, tế bào lớn dần. Chúng chỉ bé như dấu chấm và manh nha tăng trưởng thành phôi thai. Tiếp theo, chúng sẽ tăng trưởng thành những tế bào khác nhau, trong đó có não. Chúng được đưa sang một đĩa cấy khác, và cho ăn protein ít đi. Các phần còn lại chết dần, chỉ còn lại tế bào não với sức sống dẻo dai .
Cuối cùng, phần não được tách ra nuôi cấy riêng trong môi trường tự nhiên giống như hộp sọ. Cuối cùng là chờ đón. Sau 3 tháng, chúng to khoảng chừng 4 mm, chứa 2 triệu neuron. Các neuron này khởi đầu phát tín hiệu. Đây là một thành tựu cho thấy những neuron đang hoạt động giải trí. Trường hợp này giống như tế bào tim cấy năm 2013 có tín hiệu muốn bơm máu .
Các khay nuôi cấy não
Tại thời gian này, não do Lancaster nuôi cấy chưa hoàn toàn có thể tư duy. Không rõ chính sách phát sinh tâm lý của bộ não. Xét trên con người thì não cần kích thích từ môi trường tự nhiên bên ngoài. Vì vậy nếu không có khung hình, não không hề tăng trưởng thông thường. Tuy những neuron thao tác nhưng chúng không có mối link với nhau. Có thể thấy điều đó ở những người mù bẩm sinh. Phần não phân biệt ánh sáng của họ không hình thành .
Tương tự nếu sử dụng điện não đồ, màn hình hiển thị sẽ không hiển thị bất kể điều gì. Sóng não được hàng triệu tế bào phát tín hiệu đồng nhất trải qua da đầu. Dù vậy, tạo ý thức cho não nhân tạo không phải là tiềm năng của Lancaster, mà cô đang cố giải đáp huyền bí rằng tại sao con người lại khác tinh tinh tới vậy trong khi độc lạ gen chỉ là 1,2 % .
Nhóm điều tra và nghiên cứu đã cấy ghép não người lai tinh tinh và phát hiện não tinh tinh có ít neuron hơn, và thể tích nhỏ hơn. Có nghĩa là việc nuôi cấy này giúp họ không cần làm thí nghiệm vi phạm nhân đạo như thêm gen tinh tinh vào bào thai để nghiên cứu và phân tích theo kỹ thuật cũ .
Bên cạnh đó, còn một nhóm khác đang tìm cách cải thiện não bộ như tăng lượng máu. Thành công của Lancaster còn mở ra cánh cổng mới trong nghiên cứu các bệnh như tự kỷ, trong đó có cơ chế hoạt động thiếu cân bằng của neuron kích thích và neuron ức chế. Trước kia, việc nghiên cứu não trên người sống là bất khả thi.
Cuối cùng, giới khoa học đang nóng lòng để đạt tới tiềm năng nuôi cấy một bộ não hoàn hảo như của người thường. Nhưng lúc này, họ vẫn phải bằng lòng với những miếng ” bỏng ngô ” vì đó là tác dụng khả thi nhất trong hiện tại.
